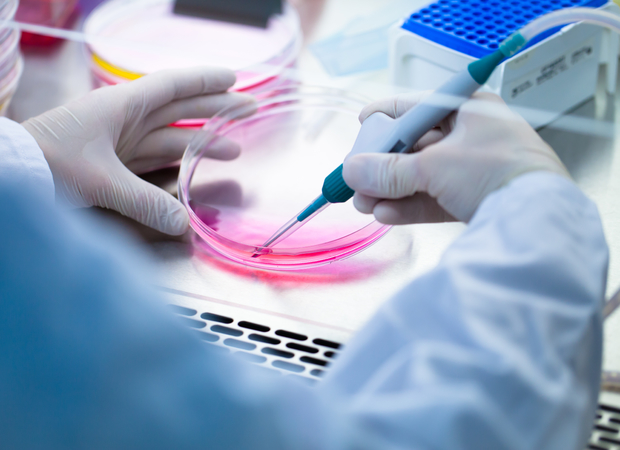

Áttörés: köldökzsinórvérrel gyógyítható a rettegett betegség

Gyógyulás őssejttel
A betegek saját köldökzsinórvérével történő infúziós kezelés egyes betegségeknél esélyt jelenthet a gyógyulásra. Magdalena Chrościńska-Krawczyk professzor úgy véli, hogy az eredmények igen ígéretesek. A szülés során gyűjtött őssejtek az utóbbi években már részét képezték egyes orvosi kísérleti kezeléseknek. Több eset is akadt, amikor a gyerekek köldökzsinórvérét használták fel. A kezelés kísérleti szakaszában14 kis páciens vett részt, a kutatási eredményeink pedig azt igazolják, hogy a neurológiai betegségben szenvedő páciensek életminőségében jelentős a javulás.